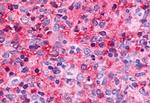
NR5A2 Antibody in Immunohistochemistry (Paraffin) (IHC (P))

Search
Invitrogen
NR5A2 Polyclonal Antibody
{{$productOrderCtrl.translations['antibody.pdp.commerceCard.promotion.promotions']}}
{{$productOrderCtrl.translations['antibody.pdp.commerceCard.promotion.viewpromo']}}
{{$productOrderCtrl.translations['antibody.pdp.commerceCard.promotion.promocode']}}: {{promo.promoCode}} {{promo.promoTitle}} {{promo.promoDescription}}. {{$productOrderCtrl.translations['antibody.pdp.commerceCard.promotion.learnmore']}}
产品信息
PA5-34017
种属反应
宿主/亚型
分类
类型
抗原
偶联物
形式
浓度
规格
纯化类型
保存液
内含物
保存条件
运输条件
RRID
靶标信息
Binds to the sequence element 5'-AACGACCGACCTTGAG-3' of the enhancer II of hepatitis B virus genes, a critical cis-element of their expression and regulation. May be responsible for the liver-specific activity of enhancer II, probably in combination with other hepatocyte transcription factors. Key regulator of cholesterol 7-alpha-hydroxylase gene (CYP7A) expression in liver. May also contribute to the regulation of pancreas-specific genes and play important roles in embryonic development.
仅用于科研。不用于诊断过程。未经明确授权不得转售。
篇参考文献 (0)
生物信息学
蛋白别名: Alpha-1-fetoprotein transcription factor; B1-binding factor; b1-binding factor, hepatocyte transcription factor which activates enhancer II of hepatitis B virus; CYP7A promoter-binding factor; fetoprotein-alpha 1 (AFP) transcription factor; FTF; FTF; similar to nuclear hormone receptor; FTZ F1; FTZ F1beta; hB1F; hB1F 2; Hepatocytic transcription factor; hepatocytic transcription factor hB1F-3; live; Liver receptor homolog 1; LRH-1; Nuclear receptor subfamily 5 group A member 2; nuclear receptor; similar to FTZ-F1; orphan nuclear receptor; steroidogenic factor 2; unnamed protein product
基因别名: B1F; B1F2; CPF; FTF; FTZ-F1; FTZ-F1beta; hB1F-2; LRH-1; LRH1; NR5A2; SF-2
UniProt ID: (Human) O00482
Entrez Gene ID: (Dog) 490252, (Bovine) 541305, (Human) 2494, (Horse) 100009700, (Pig) 100523688, (Sheep) 100653388